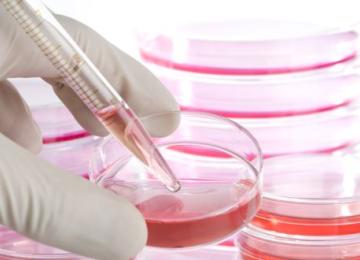

Kurdestan Province in western Iran has been hit by a wave of dust storms since Sunday evening, plunging the region’s air quality to dangerously low levels and reducing visibility to less than 100…
People
<p>Iran people news, Read the latest news on Iran's society, including developments in sciences, education, universities, and students, along with stories about Iran health sector. </p>
- People
Eco-conscious commuters now have a new option for getting around some of Finland’s urban centers. Battery-assisted bike taxis became part of the landscape in Helsinki, Kuopio and Porvoo, providing…
PeopleAt present, 15% of Tehranis are suffering from diabetes and an additional 15% are in the pre-diabetes stage, said Freydoun Azizi, head of the Endocrine Research Center. “During the last two…
PeopleThe annual per capita consumption of seafood in Iran is 10 kg as against the global per capita fish consumption of more than 20 kg, said Hassan Salehi, head of the Fisheries Organization.
PeopleThere is some evidence to indicate that it’s not just men who physically abuse the opposite sex. In the first seven months of the previous year that ended in March, nearly 1,350 men filed domestic…
PeopleA research team led by Iranian researcher Ali Khademhosseini at the Massachusetts Institute of Technology, has managed to grow artificial heart, liver, and skin tissues. “These tissues, produced…
PeopleRussia’s National University of Science and Technology (NUST-MISIS) has hosted for the first time a delegation from the renowned Iranian K. N. Toosi University of Technology.
PeopleThe Majlis Research Center has called on the incumbent government to take compensatory measures in areas where the previous government fell short with regards to rural communities and their…
PeopleThe World Health Assembly (WHA) which concluded its 69th session on May 28 in Geneva, adopted three global health sector strategies on HIV, viral hepatitis and sexually transmitted infections (…
PeoplePrevious research has shown that migraine is a risk factor for stroke and a recent study demonstrates that migraine might also be a risk factor for cardiovascular disease and mortality.
…
PeopleSome 230 Syrian and international experts joined forces in a two-day meeting to assess damage to cultural heritage sites in Syria, develop methodologies and define priority emergency safeguarding…
PeopleA group of Iraqi businesses will invest $28 million for the construction of a five-star hotel in Abadan, Khuzestan Province which will begin soon after a plot of land is provided by the Iranian…
PeopleFollowing reports that some hotels have been turning single women away by coming up with excuses to refuse service, the president of the Iranian Hoteliers’ Association has vocally criticized hotel…
PeopleThe global airline industry association’s head said terrorist attacks on aircraft, airports and tourist destinations of the kind that have ripped through Europe and parts of northern Africa in the…
PeopleA vote to leave the European Union this month could cost the UK’s tourism industry as much as £4.1 billion ($5.9 billion) a year in international tourist spending alone.
PeopleThe project to turn Hendurabi Island in the Persian Gulf into a tourist resort – or the ‘Island of Peace’ as the advocates of the scheme call it – has been suspended due to a number of…
PeopleWhether social harms are more common in city fringes or in their central parts was the subject of a recent debate, with experts calling for more government support to NGOs since they play an…
PeopleWorld Health Organization officials on Friday cautioned that “many thousands” of infants infected with Zika virus could suffer neurological abnormalities and said nations dealing with an outbreak…
PeopleHeavy rainfall and flashfloods over the past 72 hours have affected four Iranian provinces. “Ardabil, Khorasan Razavi, North Khorasan, and Mazandaran were hit by sudden floods triggered by heavy…
PeopleFive specialized MS clinics will be launched in Isfahan, Tehran, Khorasan Razavi, East Azarbaijan and Fars provinces which have the highest number of patients with multiple sclerosis, said…
PeopleThe 4th Iran International Public Health Summer School has announced registration for late entries from June 2. Students can register till June 14.
PeopleEffective implementation of a comprehensive scheme on women empowerment is on the agenda of the Women’s Faction in the 10th Majlis (parliament), said Soheila Jelodarzadeh, a newly-elected lawmaker…
PeopleA memorandum of understanding for scientific cooperation was signed between Tehran University’s International Campus on Kish Island and the Polytechnic University of Milan. The MoU was signed…
PeopleThe latest hurdle holding up the implementation of Low Emission Zone Plan is the debate over how much access the centralized system for vehicle technical inspection should have to people’s…
PeopleIn a bid to save Gorgan Bay from desiccation, 100 billion rials ($2.8 million) has been earmarked for dredging the Khazini and Chapoghli channels, the main tributaries of the Bay.
People